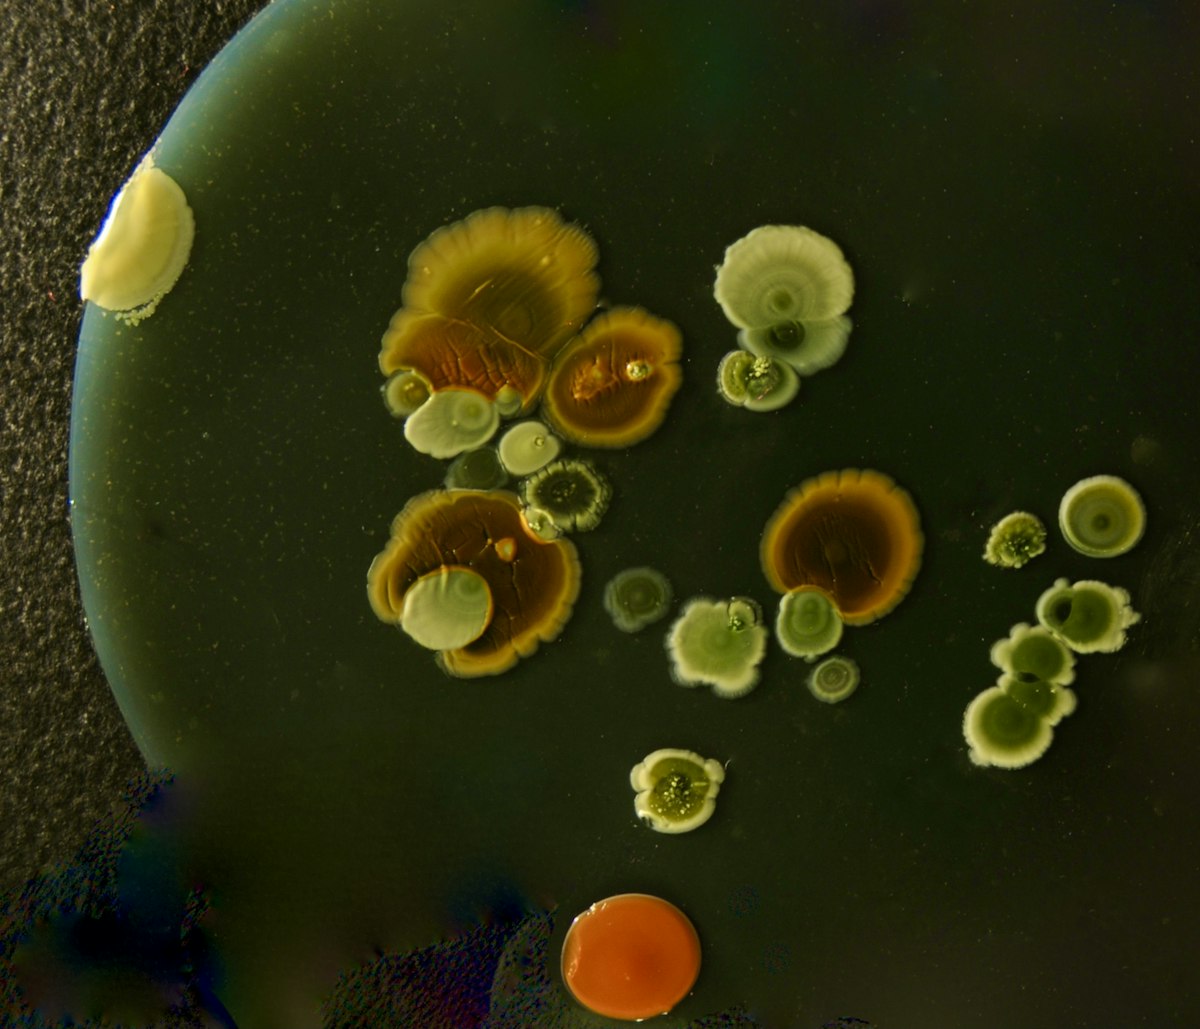
실험실 평판에서 배양된 세균 군집의 색색 콜로니

대체당은 혈당에 무해할까? 스테비아·알룰로스 비교
제로 음료에 흔히 쓰이는 대체당 5종을 혈당·장내 미생물·장기 안전성 축으로 비교
제로 콜라, 제로 사이다, 제로 막걸리 — 편의점 매대에서 '제로' 라벨을 보는 일이 당연해진 시대예요. 2025년 한국 식품산업협회 자료에 따르면 국내 탄산음료 매출에서 제로 계열 비중이 40%를 넘어서며 역대 최고치를 기록했어요. 그런데 '제로 = 혈당을 안 올리는 음료'가 정말 맞을까요. 스테비아·알룰로스·에리스리톨처럼 혈당을 거의 올리지 않는 대체당이 있는 한편, 수크랄로스·아스파탐처럼 인슐린 반응과 장내 미생물 변화를 둘러싼 논란이 남아 있는 감미료도 있어요. 이 글은 시판 제로 음료에 흔히 쓰이는 대체당 5종을 혈당 영향·임상 근거·장기 안전성 세 축에서 정리합니다.

🥤 대체당은 왜 혈당을 올리지 않을까요?#
대체당은 설탕과 비슷한 단맛을 내지만 탄수화물을 거의 포함하지 않거나, 몸에서 흡수되지 않아 혈당을 거의 올리지 않는 감미료를 통틀어 말해요. 설탕 1g은 약 4 kcal의 열량과 함께 포도당·과당을 혈액으로 공급하지만, 대체당 대부분은 소장에서 흡수되지 않고 배출되거나 아주 미량만 흡수돼요. 다만 '혈당을 올리지 않는다'와 '몸에 전혀 영향이 없다'는 서로 다른 질문이에요.

설탕(수크로스)은 포도당 한 분자와 과당 한 분자가 결합한 이당류예요. 장에서 효소로 분해되자마자 포도당이 혈액으로 들어가 식후 혈당을 빠르게 올리고, 인슐린 분비를 자극해요. 2013년 미국심장협회(AHA) 보고서에 따르면 하루 첨가당을 여성 25g, 남성 36g 이하로 줄여야 심혈관 건강에 유리하다고 제안되었어요. 현실은 반대 방향이어서, 2022년 한국 보건복지부 국민건강영양조사에서 성인 평균 첨가당 섭취량은 하루 37g으로 권고량을 웃돌고 있어요.
대체당은 설탕의 이 공백을 메우기 위해 개발된 단맛 물질을 통칭해요. 크게 세 갈래로 나뉘어요. 첫째, 식물에서 추출한 고감미 배당체예요. 대표 주자는 스테비아와 몽크후르츠(나한과) 추출물이에요. 둘째, 탄수화물 구조이지만 몸에서 거의 흡수되지 않는 당알코올이에요. 에리스리톨·자일리톨·말티톨이 여기 속해요. 셋째, 실험실에서 합성한 고감미 화합물이에요. 수크랄로스·아스파탐·사카린이 대표예요.
혈당을 올리지 않는 구조적 이유는 두 가지예요. 하나, 분자 구조가 포도당과 달라서 위장 효소가 분해하지 못해요. 스테비올 배당체와 수크랄로스가 이 경우예요. 둘, 분해되더라도 일부만 흡수되거나 신장에서 소변으로 바로 배출돼요. 알룰로스·에리스리톨이 이 경로를 따라요.
한 가지 더 짚고 갈 부분은 '단맛을 느끼는 입맛 자극'과 '실제 혈당 반응' 이 완전히 같지는 않다는 점이에요. 일부 연구에서는 혀에서 단맛을 감지한 순간 뇌에 '열량이 들어온다'는 신호가 전달되어 인슐린이 미리 살짝 분비되는 현상, 즉 세팔릭 인슐린 반응(cephalic phase insulin release)이 보고됐어요. 하지만 이 반응의 크기는 실제 설탕을 먹었을 때보다 훨씬 작고, 메타분석에서도 일관되게 재현되지는 않았어요. 현재 임상 합의는 "대체당 자체가 식후 혈당을 올리는 힘은 설탕의 10분의 1 수준 이하" 로 요약돼요.
🌿 스테비아·알룰로스·에리스리톨, 3종은 어떻게 다를까요?#
스테비아·알룰로스·에리스리톨은 모두 "혈당을 거의 올리지 않는다" 는 공통점을 갖지만, 유래·감미도·대표 단점은 각각 달라요. 스테비아는 남미 원산 식물 잎에서 추출한 고감미 배당체예요. 알룰로스는 밀·건포도·무화과에 미량 존재하는 희소당으로, 칼로리가 포도당의 10분의 1 수준이에요. 에리스리톨은 옥수수 전분을 효모로 발효해 만드는 당알코올로, 섭취량의 90% 이상이 소변으로 배출돼요.

스테비아(Stevia) 는 1931년 프랑스 화학자 M. Bridel과 R. Lavielle이 잎에서 스테비오사이드를 분리한 이래 남미에서 오랫동안 허브 감미료로 쓰였어요. 2008년 미국 FDA가 스테비올 배당체를 GRAS(Generally Recognized As Safe) 등급으로 인정했고, 한국은 2009년 식약처가 식품첨가물로 지정했어요. 단맛은 설탕의 200–300배로 매우 강해서 실제 제품에 들어가는 양은 극소량이에요. 혈당 영향을 본 임상은 2010년 Anton 등의 연구가 자주 인용돼요. 대사증후군 성인 19명에게 스테비아·설탕·아스파탐을 전처치로 제공한 뒤 식후 혈당과 인슐린을 측정했는데, 스테비아군의 식후 혈당 곡선 아래 면적(AUC)이 설탕군보다 유의하게 낮았어요.
알룰로스(Allulose) 는 자연계 미량 성분으로 존재하는 희소당(rare sugar)이에요. 화학식은 과당과 같지만 6번째 탄소의 입체 구조만 다른 에피머예요. 입에서는 설탕의 약 70% 단맛으로 느껴지고, 1g당 열량은 약 0.4 kcal로 거의 무시할 수준이에요. 2020년 미국 FDA는 알룰로스가 수크로스(설탕)와 다르게 대사되므로 영양성분표의 "Added Sugars(첨가당)" 와 "Total Sugars(당류)" 에서 제외할 수 있다고 규정했어요. 체내에서 약 70% 가 흡수되지만 대사되지 않고 신장을 통해 소변으로 배출되는 경로를 따라요. 한국은 CJ제일제당과 삼양사가 주력 제조사이고, 2024년 이후 시판 제로 음료·디저트류에서 빠르게 채택되고 있어요.
에리스리톨(Erythritol) 은 당알코올 중에서 몸에서 가장 흡수되지 않는 편에 속해요. 옥수수 등 전분을 효모로 발효해 만드는 물질로, 단맛은 설탕의 약 70%, 열량은 1g당 0.2 kcal예요. 섭취한 양의 약 90%는 흡수된 뒤 대사되지 않고 소변으로 배출되고, 나머지는 대장으로 내려가 배설돼요. GI(혈당지수)는 0으로 측정되고, 2021년 Mazi 등이 발표한 메타분석에서 식후 혈당·인슐린에 의미 있는 변화가 관찰되지 않았어요. 다만 2023년 2월 Cleveland Clinic이 Nature Medicine에 발표한 연구에서는, 심혈관 고위험군에서 혈중 에리스리톨 농도가 높을수록 3년 내 심혈관 사건 발생 위험이 커지는 상관관계가 관찰돼 논란이 됐어요. 다만 이는 인과관계가 입증된 무작위 시험이 아니라 관찰 코호트 연구라는 점은 염두에 두어야 해요.
| 항목 | 스테비아 | 알룰로스 | 에리스리톨 |
|---|---|---|---|
| 유래 | 식물(스테비아 잎) 추출 배당체 | 자연 미량 희소당(과당 에피머) | 당알코올(전분 발효) |
| 감미도(설탕=1) | 200–300× | 0.7× | 0.7× |
| 열량 (kcal/g) | ≈ 0 | 0.4 | 0.2 |
| 식후 혈당 반응 | 거의 없음 | 거의 없음 | 거의 없음 |
| 대표 단점 | 쓴 뒷맛 | 과량 시 복부 팽만 | 찬 감각·심혈관 관찰 연구 논란 |
| 국내 허가 연도 | 2009 (식약처) | 2015 (식약처) | 2000 (식약처) |
당알코올 공통 주의점은 "한 번에 많이 먹으면 배가 부글거릴 수 있다"는 점이에요. 대장까지 내려간 당알코올은 장내 세균이 발효해 짧은사슬지방산과 가스를 만들어 내요. 에리스리톨은 당알코올 중에서 내성이 가장 좋은 편이지만, 체중 70 kg 성인을 기준으로 1회 50g 이상을 단독 섭취하면 복부 팽만·설사를 경험할 수 있어요.
⚗️ 수크랄로스·아스파탐, 인공감미료는 안전할까요?#
수크랄로스와 아스파탐은 각각 설탕의 600배·200배 단맛을 내는 합성 감미료예요. 2023년 7월 세계보건기구(WHO) 산하 국제암연구소(IARC)가 아스파탐을 "Group 2B — possibly carcinogenic to humans" 로 분류하면서 논란이 커졌어요. 하지만 같은 날 유엔 식품첨가물 전문가위원회(JECFA)는 기존 일일섭취허용량(ADI) 40 mg/kg을 유지해, "적정량 내 섭취는 위험하지 않다"는 입장을 재확인했어요. 두 전문가 기구의 결론이 서로 다른 방향을 가리키는 영역이라는 점을 먼저 짚고 가면 해석이 쉬워져요.
수크랄로스(Sucralose, 상품명 Splenda) 는 1976년 영국 Tate & Lyle 연구소에서 우연히 발견된 물질이에요. 설탕 분자의 수산기(-OH) 세 개를 염소(Cl)로 치환한 구조라 단맛은 그대로지만 소화 효소가 분해하지 못해요. 섭취량의 약 85%가 흡수되지 않고 대변으로 배출돼요. 열에 비교적 안정적이어서 베이킹용 감미료로도 쓰여요. 1991년 캐나다를 시작으로 1998년 미국 FDA, 2004년 EU, 2000년 한국 식약처가 차례로 허가했어요. ADI는 체중 1 kg당 15 mg예요.
수크랄로스 안전성 논란은 2016년 이탈리아 Ramazzini Institute가 발표한 쥐 실험에서 출발했어요. 고용량 수크랄로스 노출군에서 백혈병 발생률 증가가 관찰됐다는 내용이었는데, 미국 FDA와 유럽식품안전청(EFSA)은 실험 방법론의 한계와 다른 대규모 연구에서 일관된 결과가 나오지 않는다는 이유로 기존 허가를 유지했어요. 다른 한쪽에서는 2018년 Journal of Toxicology and Environmental Health의 리뷰 논문이 수크랄로스가 고온에서 염화 합성물을 형성할 가능성을 제기해, "섭씨 120도 이상으로 가열 조리하는 요리에는 사용을 자제하라" 는 실용 조언이 이어졌어요.
아스파탐(Aspartame, 상품명 NutraSweet) 은 1965년 미국 G.D. Searle사 연구원이 우연히 발견했어요. 아미노산인 아스파르트산과 페닐알라닌을 결합한 디펩타이드예요. 입에서 단맛을 느낀 뒤 장에서 분해되면 원래의 아미노산과 극소량의 메탄올로 바뀌어 일반 식품 대사 경로로 흡수돼요. 바로 그 페닐알라닌 때문에 페닐케톤뇨증(PKU) 환자는 아스파탐을 반드시 피해야 해요. 제품 라벨에 "페닐알라닌 함유" 문구가 의무적으로 표기되는 이유예요.
2023년 7월 14일 IARC의 2B 분류는 전 세계 뉴스를 탔지만, 분류 체계를 이해하면 체감 위험도가 조금 달라져요. Group 2B는 "사람에서의 증거는 제한적이고 동물실험 증거도 제한적" 일 때 붙는 범주예요. 같은 카테고리에 알로에 베라 전체 잎 추출물, 휴대전화 전자기파, 절인 채소류가 들어가 있어요. 반면 JECFA는 체중 70 kg 성인이 350 mL 다이어트 콜라 기준 하루 9–14캔 이상을 매일 마셔야 ADI를 넘는다고 계산했어요. 한국 식약처도 2023년 8월 보도자료에서 기존 허가를 유지한다고 밝혔어요.
| 물질 | 유형 | 주요 임상 논란 | 현행 국제 기구 입장 |
|---|---|---|---|
| 스테비아 | 식물 추출 천연 | 장내 미생물 변화(경미) | WHO·FDA·식약처 허가 |
| 알룰로스 | 희소당 | 대용량 시 복부 팽만 | FDA 당류 제외 인정(2020) |
| 에리스리톨 | 당알코올 | 2023 심혈관 코호트 상관관계 | WHO·FDA·식약처 허가 |
| 수크랄로스 | 합성 감미료 | 고온 분해·장내 미생물 변화 | ADI 15 mg/kg 유지 |
| 아스파탐 | 합성 감미료 | IARC 2B 분류(2023) | JECFA ADI 40 mg/kg 유지 |
정리하자면 수크랄로스와 아스파탐 모두 현재 국제 식품 안전 기관의 허가 범위 안에서 판매되고 있고, 일상적 섭취량에서 곧바로 건강 위해를 일으킨다는 결정적 증거는 아직 확립되지 않았어요. 동시에 장기 복용의 미묘한 영향에 대한 연구는 계속 쌓이고 있는 중이라는 점도 사실이에요. 두 현실이 공존하는 영역이라는 관점이 가장 정직해요.
🔬 매일 마셔도 괜찮을까요? 장기적 영향은?#
단기적인 식후 혈당 반응에서는 대체당이 설탕을 대신해 혈당 스파이크를 줄이는 효과가 반복 관찰돼요. 반면 "매일 다량 섭취 시 대체당이 장기적으로도 안전한가" 라는 질문에는 아직 연구가 쌓이고 있는 과도기예요. 장내 미생물 프로필 변화, 단맛 신호가 식욕 조절 회로에 주는 영향, 그리고 "제로 음료라서 마음껏 먹어도 된다"는 행동 변화 세 갈래가 주요 논의 포인트예요.
가장 많이 인용되는 연구는 2022년 8월 Cell에 발표된 이스라엘 Weizmann 연구소 Eran Elinav 팀의 실험이에요. 건강한 성인 120명을 6개 군으로 나눠 2주 동안 사카린·수크랄로스·아스파탐·스테비아 4종의 비영양 감미료 또는 포도당 대조군을 각각 복용시켰어요. 결과로 4종 감미료 모두 장내 미생물 구성에 변화를 일으켰고, 그중 사카린·수크랄로스군은 경구당부하검사(OGTT)에서 내당능까지 일부 저하되는 양상을 보였어요. 스테비아는 미생물 변화는 관찰됐지만 혈당 내성에는 통계적으로 유의한 변화가 없었어요. 대상이 120명으로 소규모이고 기간이 2주로 짧다는 한계는 있지만, "비영양 감미료가 아무 일도 일으키지 않는다" 는 가정을 깨뜨린 연구라는 점에서 의미가 커요.
행동 쪽 관점도 중요해요. 2017년 Imperial College London의 Christopher Gardner 등이 BMJ에 발표한 체계적 리뷰는 인공감미료를 장기 복용하는 인구군에서 오히려 체중 감소 효과가 평균적으로 관찰되지 않았다고 보고했어요. 해석으로는 두 가지 가설이 있어요. 하나, 뇌의 보상 회로가 단맛 신호에 반복 노출되면 단 음식을 더 원하는 쪽으로 적응한다는 가설이에요. 둘, "제로 음료니까 칼로리가 없다" 는 심리가 전체 식사에서 고열량 음식 선택을 늘린다는 행동 경제학적 가설이에요. 2021년 JAMA Network Open에 발표된 UCLA Alaina Pearce 팀 연구는 fMRI로 뇌 보상 회로 반응을 관찰해, 수크랄로스 섭취가 식사 후 뇌의 뇌시상하부·보상 회로 활동을 변화시킨다는 결과를 보고해 이 가설에 무게를 실었어요.
심혈관·전체 사망 관점에서는 2022년 BMJ에 발표된 프랑스 NutriNet-Santé 코호트 분석이 자주 인용돼요. 성인 약 10만 명을 평균 9년간 추적한 결과, 인공감미료 섭취 최상위군이 최하위군 대비 심혈관 사건 발생 위험이 9% 높은 상관관계를 보였어요. 다만 관찰 코호트이므로 인과관계를 입증한 결과는 아니라는 한계가 논문 원문에도 분명히 적혀 있어요. 한국인 데이터는 아직 축적이 부족해 직접 적용에 주의가 필요하고, 반대 방향 결과도 함께 존재해요. 2023년 Cochrane Review는 설탕을 저영양 감미료로 대체했을 때 단기적으로 체중·혈당 관리에 유리하다는 메타분석 결과를 제시했어요.
당뇨 환자·혈당 관리 중인 인구에서의 권고는 상대적으로 명확한 편이에요. 미국당뇨병학회(ADA)가 2024년에 발표한 생활습관 가이드라인은 "설탕 대체 목적의 저영양 감미료가 체중·혈당 단기 관리의 보조 도구가 될 수 있다" 고 기술해요. 이 권고는 기본 원칙에 덧붙는 부가 수단이라는 점이 핵심이에요. 기본 원칙은 전체 섭취 칼로리 균형, 식이섬유·단백질 충분 섭취, 규칙적 운동이라는 점이 먼저 놓이고, 그 바탕에서 설탕을 대체당으로 바꿀 때 혈당 관리 이익이 커진다는 해석이에요.
✨ 정리하면#
대체당은 혈당을 거의 올리지 않는다는 점에서 설탕의 유용한 대체재가 될 수 있어요. 그중 스테비아·알룰로스·에리스리톨은 식품 허가와 임상 근거가 가장 안정적으로 쌓인 대체당 3종이에요. 수크랄로스·아스파탐은 국제 식품 안전 기관의 ADI 안에서 허가된 상태이지만, 장내 미생물 변화와 발암성 분류를 둘러싼 논란이 남아 있어 장기 연구가 계속되고 있어요. 대체당을 일상에서 선택할 때 가이드라인은 "제로 음료 = 물이 아닌, 설탕 음료를 대체한 결과" 라는 틀에서 시작하면 혈당 관리와 전체 식단 균형을 같이 잡기 쉬워요.
- 제로 음료 라벨의 '원재료' 항목에서 감미료 종류 확인하는 습관 들이기
- 갈증 해소 1순위는 물·보리차·녹차로, 제로 음료는 설탕 음료 대체 용도로 쓰기
- 당알코올 함유 디저트는 1회 섭취량 20g 이내에서 시작해 몸 반응 살피기
- 페닐케톤뇨증이 있는 가족이 있다면 아스파탐 함유 표기 꼼꼼히 확인하기
- 혈당 관리 중이라면 '제로 = 마음껏' 이 아닌 전체 식단 균형의 일부로 접근하기
이 글은 일반 건강 정보이며 개인의 진단이나 치료를 대신하지 않습니다. 걱정되는 증상이나 변화가 있다면 가까운 병원에서 전문의와 상담하세요.
자주 묻는 질문
- 제로 콜라 하루 2캔, 괜찮을까요?
- 아스파탐 기준 ADI(일일섭취허용량)는 체중 1 kg당 40 mg이에요. 체중 70 kg 성인은 하루 2,800 mg 상한이 되고, 350 mL 다이어트 콜라 한 캔에 아스파탐이 약 180–200 mg 들어 있다고 계산하면 하루 14캔 이상을 매일 마셔야 상한에 도달해요. 하루 2캔은 안전 허용 범위 안이에요. 다만 카페인·탄산·산도에 의한 위장 자극, 그리고 단맛 의존이라는 행동 측면은 별도로 고려할 부분이에요.
- 알룰로스는 왜 변기 물 빠지듯 배출된다고 하나요?
- 알룰로스는 섭취 후 약 70%가 소장에서 흡수되지만 몸 안에서 대사되지 않고 약 24시간 안에 신장을 통해 소변으로 빠져나가요. 나머지는 대장에서 일부 미생물 발효를 거쳐 짧은사슬지방산으로 전환돼요. 따라서 열량이 거의 붙지 않고 혈당 반응도 거의 일으키지 않아요. 단, 1회 20g 이상 섭취하면 사람에 따라 복부 팽만·설사가 나타날 수 있어 첫 섭취는 소량부터 늘려 가는 쪽을 권해요.
- 에리스리톨이 심혈관에 해롭다고 들었는데, 끊어야 하나요?
- 2023년 2월 Cleveland Clinic 연구팀이 Nature Medicine에 발표한 논문은 심혈관 고위험군 코호트에서 혈중 에리스리톨 농도가 높을수록 3년 내 심혈관 사건 발생률이 더 높았다는 상관관계를 보고했어요. 인과관계를 입증한 무작위 시험이 아니고, 대상군이 이미 심혈관 위험이 높았던 사람들이었다는 해석 한계가 있어요. 같은 해 International Sweeteners Association을 비롯한 여러 전문 기구가 기존 안전성 결론을 유지한다고 밝혔어요. 건강한 일반인이 지금 당장 "끊어야 한다" 고 볼 근거는 아직 충분하지 않아요.
- 당뇨가 있는 경우, 대체당을 먹는 게 낫나요?
- 미국당뇨병학회(ADA) 2024 가이드라인은 설탕 대체 목적의 저영양 감미료가 혈당·체중 관리의 보조 수단이 될 수 있다고 기술해요. 다만 음식 전체의 영양 균형을 더 중요하게 봐야 해요. 제로 음료·제로 디저트 비중이 늘면서 신선식·단백질·식이섬유 섭취가 줄어드는 역효과가 나기도 해요. 담당 주치의와 함께 전체 섭취 패턴을 먼저 정리한 뒤, 그 안에서 설탕 자리를 대체당으로 바꾸는 전략이 가장 합리적이에요.
함께 읽어요
전체 아티클 →
우유 두유 혈당 영향, 아몬드유는 어떨까요?
우유·두유·아몬드유·귀리유는 같은 음료처럼 보여도 단백질·당·인슐린 지수가 모두 다릅니다. 4종 음료의 영양 데이터와 혈당 반응을 정리하고 목적별 선택 가이드를 안내합니다.

요가 혈당 관리, 필라테스와 12주 비교
요가와 필라테스는 단발 칼로리 소모는 적지만 8–12주 누적 시 HbA1c가 평균 0.5–0.7%p 떨어진다는 메타분석이 있어요. 코르티솔·호흡 경로로 혈당이 개선되는 원리를 정리합니다.

대체면 혈당 비교: 두부면·곤약면·어묵면
면을 끊기 어렵다면 두부면·곤약면·어묵면이 대안이 될 수 있어요. 100g당 영양 성분과 식후 혈당 반응을 비교하고, 다이어트·혈당 관리·단백질 보충 목적별 선택 기준을 정리했어요.

혈당 안 올리는 과일 Top 10, GI 지수로 정리했어요
모든 과일이 똑같이 혈당을 올리진 않아요. GI 지수·당 함량·식이섬유 세 기준으로 혈당 친화 과일 Top 10을 정리하고, 함께 먹으면 좋은 조합까지 알려드려요.

저탄수 vs 저GI 식단 — 혈당 관리엔 어느 쪽이 효과적일까요?
저탄수 식단은 탄수화물 양을, 저GI 식단은 탄수의 흡수 속도를 줄입니다. 단기 혈당 안정화는 저탄수가, 장기 지속 가능성은 저GI가 우세하다는 연구 결과를 정리했어요.

새벽현상 혈당, 왜 공복인데도 오를까요?
전날보다 자고 일어난 공복 혈당이 더 높다면 새벽현상일 수 있어요. 새벽 3–8시 호르몬 변화와 소모기 효과 감별법, 안정화 전략을 정리합니다.